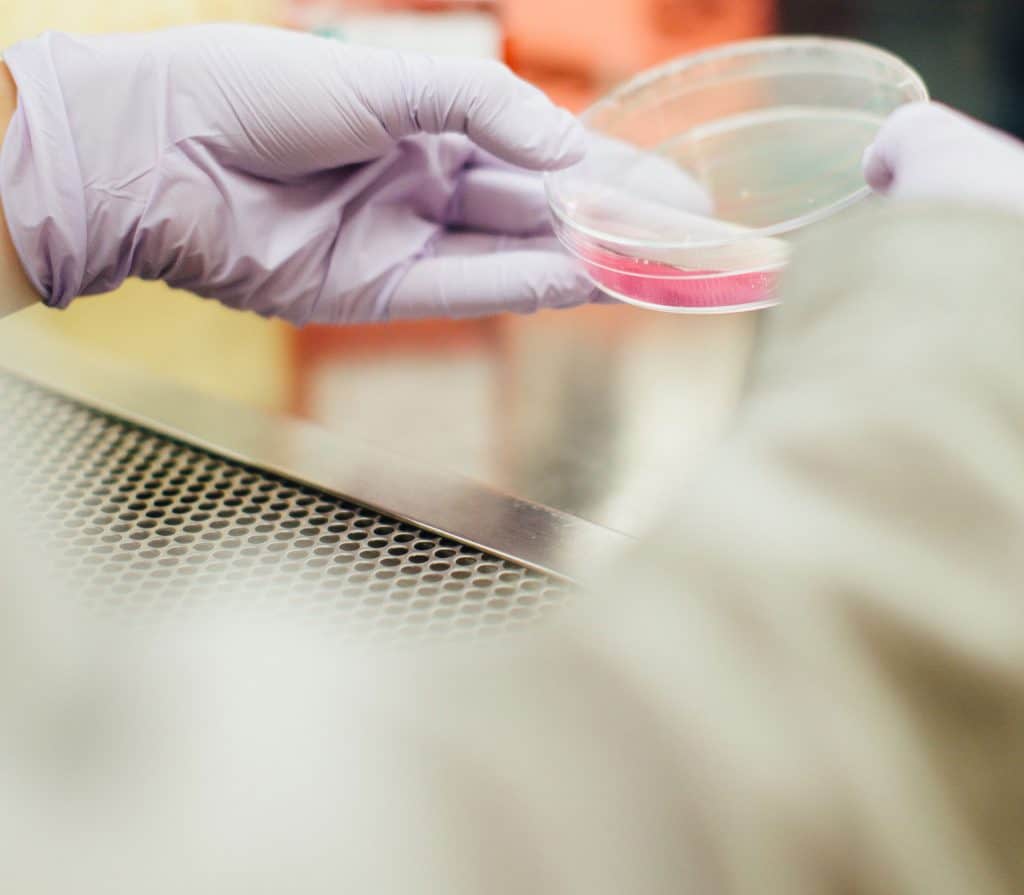

Pre-Cancerous Condition Considered a Disability
Friday 16th March 2018
In the recent case of Lofty v Hamis t/a First Café, the Claimant worked as a café assistant at First Café. Around August 2015, she became aware of a blemish on her cheek and sought medical advice about the mark. Following a biopsy, her consultant dermatologist told her that she was suffering from a condition called lentigo maligna. The Claimant’s consultant described it as a ‘pre-cancerous’ lesion.
The Claimant was signed off work due to ill health from August 2015 and underwent two operations to remove the malignant cells. These operations were successful and by mid-September, the Claimant was clear of any possible cancer. However, she continued to be signed off work for related health issues, including subsequent skin grafts and extreme anxiety.
In December, the Respondent terminated the Claimant’s employment because she had failed to attend meetings to discuss her continued absence. The Claimant brought a claim in the employment tribunal for unfair dismissal and disability discrimination.
The employment tribunal was told that the Claimant had an ‘in situ’ melanoma. This broadly means that the cancer cells were in the top layer of her skin. Cancer Research UK (CRUK) states that in situ cancers are not cancers ‘in the true sense’ because they cannot spread to other parts of the body. To that end, the employment tribunal found that the Claimant’s condition did not fall within Paragraph 6 of Schedule 1 of the Equality Act 2010 (EA). It dismissed the claim that she was discriminated against because she did not have cancer (which is automatically deemed to be a disability) and did not otherwise satisfy the definition of a disability. Separately, the Claimant’s claim for unfair dismissal was upheld.
The Claimant appealed this decision and argued that the Equality Act 2010 (EA) states that cancer is recognised as a disability and that the EA does not distinguish between forms/types of cancer; it requires only that the claimant has cancer. Further, the EA does not differentiate between how ‘serious’ the cancer is, what kind of treatment will be required, or the intensity of any such treatment. Whilst the EAT conceded that a diagnosis of ‘pre-cancerous’ cells might mean something different depending upon where the cells are to be found, the EAT found that in this case, and in terms of skin cancer, the evidence meant that the Claimant had an in situ cancer and therefore the Claimant had a disability for the purposes of the EA.